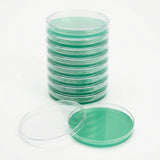
Stack of green agar petri dishes on a white background
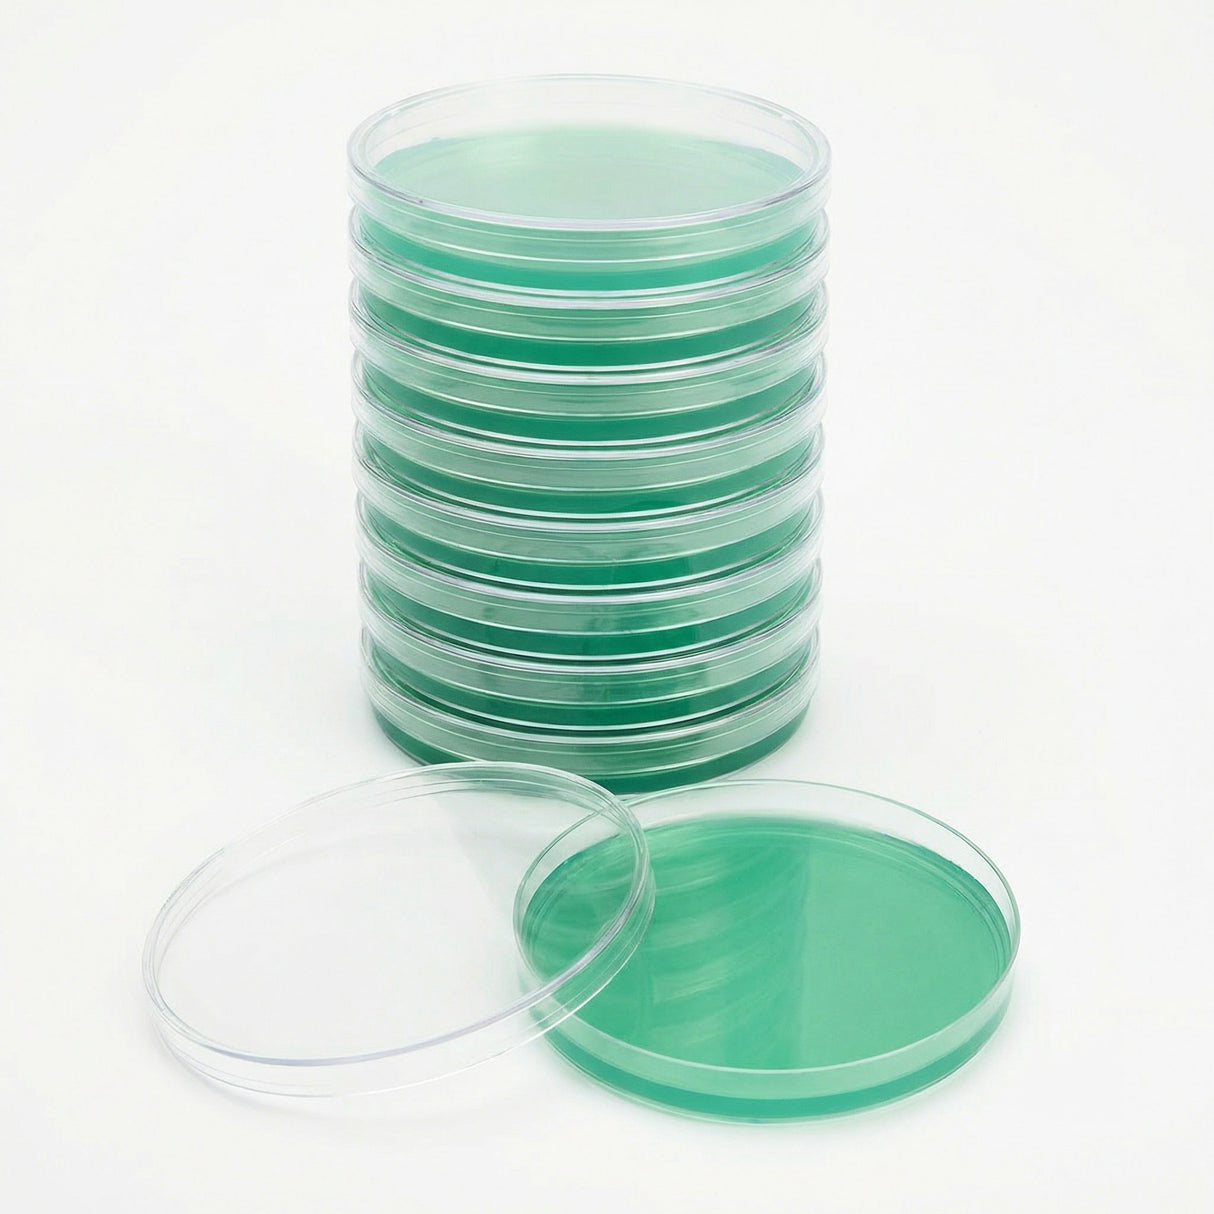
Stack of green agar petri dishes on a white background

Pre-Poured Sterilized Malt Extract Agar Plates (10-Pack)
Pre-Poured Sterilized Malt Extract Agar Plates (10-Pack) is backordered and will ship as soon as it is back in stock.
Couldn't load pickup availability
Description
Description
Pre-Poured Sterilized Malt Extract Mushroom Agar Plates (10-Pack)
Freshly Poured Daily · Premium Nutrient Blend · Ideal for Spore Germination & Early Culture Work
360° view: healthy mycelium expanding across MEA—perfect for early-stage evaluation.
Looking for the perfect agar plates for fungal culture work? Our 10-Pack of Pre-Poured Malt Extract Agar (MEA) Plates is poured fresh daily and formulated for clean, consistent mycelium development. Made from a carefully balanced blend of light malt extract, yeast extract, locust bean gum, and high-quality agar, these plates are a trusted baseline for spore germination, first transfers, and contamination checks.
Unlike agar plates that sit for weeks before shipping, ours are poured in-house, sealed in polyolefin packaging, and shipped quickly to preserve freshness and performance—ideal for mycologists, hobbyists, and lab workflows that demand consistency.
What’s Included
- (10) Pre-Poured Sterilized Malt Extract Agar Plates – ready to use out of the box
- Professional-grade Petri dishes (clear for easy observation)
- Assorted plate colors to help track batches and add visual clarity
Key Features
- Premium nutrient blend optimized for strong, healthy mycelium growth
- Ideal for spore germination and early culture development
- Consistent, lab-style workflow for repeatable results
- Assorted colors – helpful for organizing plates and tracking freshness
- Storage: refrigerate and use within 3–4 weeks for best results
Machine-Poured for Consistency & Precision
All of our agar plates are machine-poured in our clean room for uniform fill levels and reliable performance. Our process includes:
- MediaPrep sterilization at 18 PSI for 30 minutes
- Cooling to ~145°F, then precision-dispensing 25ml per plate
- UV-C sanitization, automatic capping, and laser labeling
This ensures every plate is uniform, sterile, and lab-ready.
Which Agar Plate Should I Choose?
Different agar recipes perform best at different stages—starting spores, cleaning cultures, spotting contamination, and final showcase transfers. Use this guide to pick the right plate for your workflow.
| Agar Type | Best For | Why Growers Use It | Recommended Stage |
|---|---|---|---|
| Regular LME / MEA (This Listing) | Spore germination, first plates, contamination checks | Reliable baseline media that makes early growth and contaminants easier to evaluate | Start here → first transfer |
| Rapid Rhizo | 2nd & 3rd transfers, clean isolation, showcase plates | Encourages aggressive, threadlike growth patterns that are easy to select and preserve | After first clean-up → final transfers |
| Black MEA | High visibility growth, photo-friendly plates, subtle sector spotting | Dark background increases contrast so mycelium edges, sectors, and early contaminants stand out | Any stage (especially for evaluation) |
| Manure-Enriched / Conditioning Agar | Preparing cultures for bulk substrates, performance testing | Helps “condition” cultures to richer environments and evaluate behavior on supplemented media | Mid-to-late stage (after clean culture) |
Regular LME / MEA (This Listing)
Rapid Rhizo
Black MEA
Manure-Enriched / Conditioning Agar
Workflow tip: Many growers start spores on MEA, clean up with early transfers, then finish on Rapid Rhizo to showcase final genetics.
Why Use Agar Plates in Mushroom Cultivation?
Agar is a staple in mushroom cultivation and lab culture work. Add a tiny drop of spore solution or liquid culture, incubate, and you’ll see mycelium form—allowing you to select the most vigorous growth while separating it from contaminants.
- Isolate strong genetics by selecting the fastest sectors
- Avoid contaminants by transferring only clean mycelium
- Expand cultures into grain jars, spawn bags, or liquid culture
Agar helps you control your genetics and improve consistency—whether you’re a seasoned pro or just getting started.